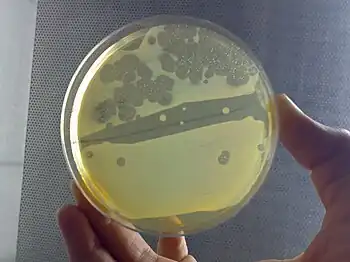

Klebsiella aerogenes
| Klebsiella aerogenes | |
|---|---|
| Scientific classification | |
| Missing taxonomy template (fix): | Escherichieae |
| Genus: | Klebsiella |
| Species: | K. aerogenes
|
| Binomial name | |
| Klebsiella aerogenes Tindall et al., 2017
| |
| Synonyms | |
| |
Klebsiella aerogenes,[2] previously known as Enterobacter aerogenes, is a Gram-negative, oxidase negative, catalase positive, citrate positive, indole negative, rod-shaped bacterium.[3]
The bacterium is approximately 1–3 microns in length, and is capable of motility via peritrichous flagella.[4]
Description
Klebsiella aerogenes is a nosocomial and pathogenic bacterium that causes opportunistic infections including most types of infections. The majority are sensitive to most antibiotics designed for this bacteria class, but this is complicated by their inducible resistance mechanisms,[5] particularly lactamase, which means that they quickly become resistant to standard antibiotics during treatment, requiring a change in antibiotic to avoid worsening of the sepsis.

Infection
Some of the infections caused by K. aerogenes result from specific antibiotic treatments, venous catheter insertions, and/or surgical procedures. K. aerogenes is generally found in the human gastrointestinal tract and does not generally cause disease in healthy individuals. It has been found to live in various wastes, hygienic chemicals, and soil. The bacterium also has some commercial significance – the hydrogen gas produced during fermentation has been experimented with using molasses as the substrate.
K. aerogenes is an outstanding hydrogen producer. It is an anaerobic facultative and mesophilic bacterium that is able to consume different sugars and in contrast to cultivation of strict anaerobes, no special operation is required to remove all oxygen from the fermenter. K. aerogenes has a short doubling time and high hydrogen productivity and evolution rate. Furthermore, hydrogen production by this bacterium is not inhibited at high hydrogen partial pressures; however, its yield is lower compared to strict anaerobes like Clostridia. A theoretical maximum of 4 mol H2/mol glucose can be produced by strict anaerobic bacteria. Facultative anaerobic bacteria such as K. aerogenes have a theoretical maximum yield of 2 mol H2/mol glucose.[6]
It may spoil maple sap and syrup.[7]
Owing to diverse metabolites, namely acids and alcohols, produced by such a strain in conjunction with its capability of utilizing different sugars, the metabolic behavior and growth of K. aerogenes can significantly vary under different conditions.[8]
Biochemical identification test results (and lab use)
| Gram | negative |
|---|---|
| Shape | rods |
| Hemolysis | negative |
| Oxidase | negative |
| Catalase | positive |
| Indole | negative |
| Citrate | positive |
| Identification Method | Test Result[11] |
|---|---|
| Motility | Positive |
| Indole | Negative |
| Methyl Red | Negative |
| VP | Positive |
| Citrate (Simmons) | Positive |
| Nitrate Reduction | Positive |
| Hydrogen Sulfide (TSI) | Negative |
| Urea Hydrolysis | Negative |
| Oxidase | Negative |
| Phenylalanine Deaminase | Negative |
| Eosin-methylene blue | Positive |
| Glucose Fermentation | Acid/Gas |
| Lactose Fermentation | Acid/Gas |
| Sucrose Fermentation | Acid/Gas |
| Mannitol Fermentation | Acid/Gas |
| Growth in KCN | Positive |
| Ornithinine Decarboxylase | Positive |
| Gelatin Hydrolysis (22 °C) | Negative |
References
- ↑ Breed, R.; Conn, H. (1936). "The Status of the Generic Term Bacterium Ehrenberg 1828". Journal of Bacteriology. 31 (5): 517–518. doi:10.1128/jb.31.5.517-518.1936. PMC 543738. PMID 16559906.
- ↑ Tindall, B. J.; Sutton, G.; Garrity, G. M. (2017). "Enterobacter aerogenes Hormaeche and Edwards 1960 (Approved Lists 1980) and Klebsiella mobilis Bascomb et al. 1971 (Approved Lists 1980) share the same nomenclatural type (ATCC 13048) on the Approved Lists and are homotypic synonyms, with consequences for the name Klebsiella mobilis Bascomb et al. 1971 (Approved Lists 1980)". International Journal of Systematic and Evolutionary Microbiology. 67 (2): 502–504. doi:10.1099/ijsem.0.001572. PMID 27902205.
- ↑ Sanders, W.E; Sanders, C.C (1997). "Enterobacter spp.: pathogens poised to flourish at the turn of the century". Clinical Microbiology Reviews. 10 (2): 220–41. doi:10.1128/CMR.10.2.220. PMC 172917. PMID 9105752.
- ↑ "Morphological Characteristics of Enterobacter aerogenes". Archived from the original on 2017-07-05. Retrieved 2017-05-07.
- ↑ Jones, Ronald N.; Baquero, Fernando; Privitera, Gaetano; Inoue, Matsuhisa; Wiedemann, Bernd (1997). "Inducible β-lactamase-mediated resistance to third-generation cephalosporins". Clinical Microbiology and Infection. 3 (s1): s7 – s20. doi:10.1111/j.1469-0691.1997.tb00643.x. ISSN 1469-0691.
- ↑ Asadi, Nooshin; Zilouei, Hamid (March 2017). "Optimization of organosolv pretreatment of rice straw for enhanced biohydrogen production using Enterobacter aerogenes". Bioresource Technology. 227: 335–344. doi:10.1016/j.biortech.2016.12.073. PMID 28042989.
- ↑ MICROBES INVOLVED IN FOOD SPOILAGE Authors: Gabriel Chavarria, Julia Neal, Parul Shah, Katrina Pierzchala, Bryant Conger
- ↑ Asadi, Nooshin; Karimi Alavijeh, Masih; Zilouei, Hamid (2018-05-03). "Biological hydrogen production by Enterobacter aerogenes: Structural analysis of treated rice straw and effect of substrate concentration". International Journal of Hydrogen Energy. 43 (18): 8718–8728. doi:10.1016/j.ijhydene.2018.03.137. ISSN 0360-3199.
- ↑ Radhakrishnan, Balachandar (6 October 2011). "_MG_7021-2". flikr. Retrieved 13 September 2024.
- ↑ Fey, Petra; Kowal, Anthony S.; Gaudet, Pascale; Pilcher, Karen E.; Chisholm, Rex L. (June 2007). "Protocols for growth and development of Dictyostelium discoideum". Nature Protocols. 2 (6): 1307–1316. doi:10.1038/nprot.2007.178. ISSN 1750-2799.
- ↑ Farmer, J J; Davis, B R; Hickman-Brenner, F W; McWhorter, A; Huntley-Carter, G P; Asbury, M A; Riddle, C; Wathen-Grady, H G; Elias, C (1985-01-01). "Biochemical identification of new species and biogroups of Enterobacteriaceae isolated from clinical specimens". Journal of Clinical Microbiology. 21 (1): 46–76. doi:10.1128/JCM.21.1.46-76.1985. ISSN 0095-1137. PMC 271578. PMID 3881471.
External links
- Enterobacter Infections at eMedicine
- "Klebsiella aerogenes". NCBI Taxonomy Browser. 548. Archived from the original on 2022-01-20. Retrieved 2023-01-18.
- Type strain of Klebsiella aerogenes at BacDive - the Bacterial Diversity Metadatabase Archived 2018-06-17 at the Wayback Machine